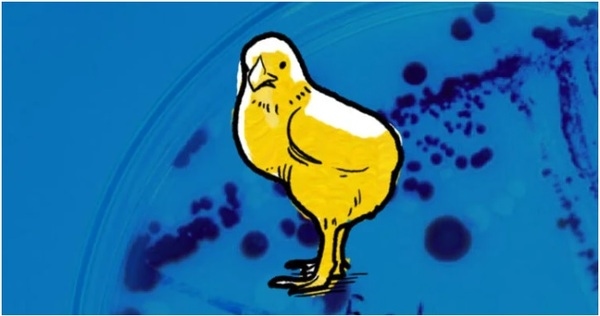

Colibacilosis: problema actual en la avicultura brasileña
Publicado: 7 de febrero de 2022
Fuente: Paulo Martins e Bauer Alvarenga
La Escherichia coli es una bacteria que habita naturalmente en los intestinos de las aves y se propaga ampliamente en la piel y las plumas. De hecho, en todo el entorno del aviario: heces, cama, polvo, alimentos, agua, ácaros, insectos…

Es un viejo conocido, presente en toda la historia de la avicultura brasileña — ¡y en todo el mundo! Según Disease of Poultry (2020), del 10 al 15% de los coliformes intestinales en aves normales pueden pertenecer a serotipos potencialmente patógenos. Lo que ha cambiado desde hace algún tiempo es la selección de cepas de E.coli patógena aviar. Los APEC (E. coli patógena aviar, del inglés Avian Pathogenic E. coli) están asociados con la colibacilosis y han sido un problema importante para la producción de pollos de engorde.
La enfermedad es económicamente devastadora. Puede afectar a aves de todas las edades, aunque los animales jóvenes son los más afectados, e impacta:
-En el aumento de la mortalidad y morbilidad; -En la ganancia menor de peso; -En el aumento de la conversión alimenticia; -En ausencia de uniformidad del lote; -El aumento de los costos de los medicamentos; -En el aumento de la condena en el matadero.
Entre las principales lesiones clínicamente observadas en campo se encuentran la onfalitis, aerosaculitis, salpingitis, peritonitis, pericarditis y celulitis.
En este artículo hablamos más sobre esta enfermedad que ha asumido el papel principal de las enfermedades avícolas, y cómo es posible prevenirla. Mantener el equilibrio de la microbiota intestinal (eubiosis) y reforzar las medidas de bioseguridad y bienestar animal son fundamentales.
APEC alcanza a todos los eslabones de la cadena productiva avícola
La colibacilosis es señalada como la principal causa de pérdidas en la avicultura brasileña, en la actualidad, debido a la alta mortalidad inicial de los pollitos y posterior condena en el matadero. Como la forma patógena de la bacteria Escherichia coli es un agente secundario, los investigadores y profesores buscan explicaciones de por qué este desafío es tan común hoy en día.
Por ser considerado un patógeno oportunista, entre las posibles causas primarias del problema se encuentran algunos virus respiratorios o inmunosupresores, uso imprudente de antibióticos, factores genéticos, estrés y manejo y condiciones ambientales, que también pueden contribuir a la aparición de la enfermedad. El hecho es que APEC continúa causando perjuicios en todos los eslabones de la cadena de producción avícola.
Estamos considerando desde bisabuelos, abuelas y matrices hasta aves comerciales que llegan al matadero para ser procesadas y vendidas.
Aunque las aves más jóvenes son más susceptibles, la enfermedad afecta tanto a los pollos de engorde como a las reproductoras en cualquier etapa de la vida. Incluso el problema puede estar muy ligado a las etapas previas al nacimiento del pollito, como la panta de incubación y/o las granjas de reproducción.
Eso es porque hay dos tipos de transmisión: vertical y horizontal. Cuando ocurre verticalmente, hay una mortalidad temprana de pollitos. Cuando hay mortalidad después de los 30 días de vida y/o decomiso en el matadero, es probable que la transmisión haya ocurrido de manera horizontal. Es decir, entre aves de un mismo aviario, entre aviarios, entre regiones, etc.
Las 6 vías principales de entrada de APEC en las aves
La ruta principal de contaminación – o punto de entrada – es la vía respiratoria. Pero no es la única:

E. coli no provoca enfermedades entéricas en las aves, pero, al ser eliminadas por las heces, permanecen viables durante mucho tiempo en la cama del aviario, que, en épocas de menor humedad del aire, suele estar muy seca, con mucho polvo. El polvo suspende la bacteria, que es inhalada por las aves y puede iniciar una enfermedad respiratoria o sistémica.
Control de la colibacilosis
La forma de controlar la colibacilosis es la prevención. Al mejorar la bioseguridad, el saneamiento, la calidad del aire (ambiente), la nutrición, la inmunidad y la calidad del pollito de un día, es posible reducir el nivel de exposición a las E. coli patógenas (APEC).
Una de las principales alternativas para actuar en el equilibrio y modulación de la microbiota intestinal de las aves (eubiosis) es el uso de probióticos. Estimulan el crecimiento y la acción de bacterias beneficiosas que compiten con las APEC. Además, estimulan el sistema inmunológico.
Qué tipo de probiótico usar y cuándo comenzar
Como el intestino de las aves está colonizado por cientos de especies de bacterias, es necesario que el probiótico utilizado pueda promover la colonización de todos los segmentos intestinales. En cada parte del órgano hay un predominio de diferentes especies. Por ello, los probióticos más indicados son aquellos compuestos por múltiples cepas, seleccionados por su capacidad de adherirse a la mucosa intestinal e inhibir las bacterias patógenas.
El momento ideal para iniciar la colonización es a partir del primer día de vida del ave. Cuando hacemos una colonización temprana con probióticos compuestos por bacterias del ácido láctico, aceleramos el crecimiento y la fijación de la microbiota intestinal. Esto será beneficioso para las aves, ya que serán más resistentes a las bacterias patógenas que suelen estar presentes en el alimento, el agua, la cama y el medio ambiente.
Vacunas Autógenas
Para controlar el problema y promover la inmunidad en reproductoras pesadas, una alternativa es el uso de vacunas autógenas. Biocamp desarrolla y fabrica vacunas autógenas con un riguroso proceso de aislamiento del agente que está infectando a las aves, además de verificar la patogenicidad de E. coli en el desarrollo de la enfermedad.
La evaluación constante del estado de salud de los lotes también es fundamental para evitar la proliferación de APEC. Si es necesario, hay que revisar los programas de vacunación de reproductoras y pollos de engorde, revisar los programas nutricionales, eliminar o reducir en lo posible los factores que provocan estrés, favorecen la disbiosis y la pérdida de inmunidad en las aves.
Temas relacionados:
Autores:
Elanco
Recomendar
Comentar
Compartir

¿Quieres comentar sobre otro tema? Crea una nueva publicación para dialogar con expertos de la comunidad.